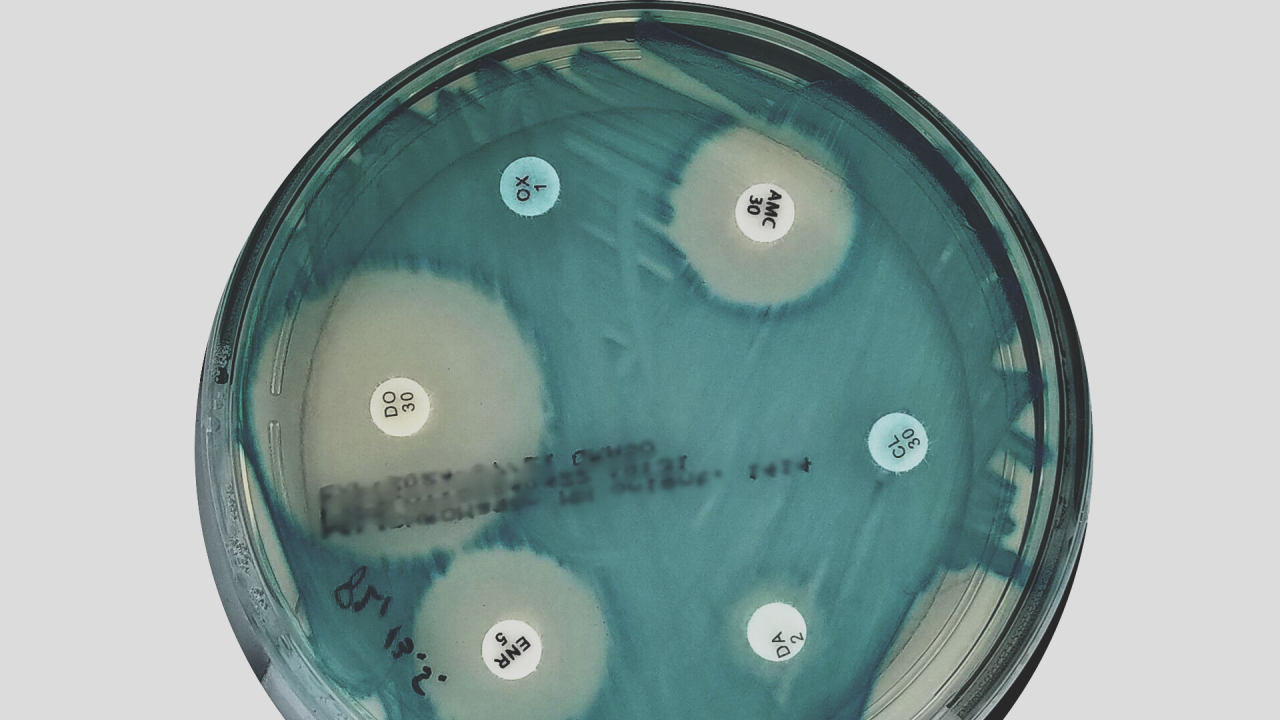
Antibiogram plate showing zones of inhibition

Rethinking AST Reporting in Veterinary Practice

Even though veterinarians are on the front lines in the battle against antimicrobial resistance (AMR)—and we pride ourselves on clinical judgment and experience—a new JAVMA study by Diaz-Campos et al. (DOI: 10.2460/javma.25.01.0045) reveals that antimicrobial susceptibility testing (AST) reporting style steers our treatment decisions more than we publicly admit. This study surveyed 216 U.S.-based veterinarians and revealed a clear message: how AST data is presented matters.
An antibiogram plate showing zones of inhibition around antibiotic discs - the basis for AST reporting
An antibiogram plate showing zones of inhibition around antibiotic discs - the basis for AST reporting
AST Reporting Preferences vs. Stewardship Behavior
One of the most striking findings from the study was the impact of cascade AST reporting on veterinarians' adherence to antimicrobial stewardship (guidelines for antimicrobial use). Cascade reporting prioritizes first-line antimicrobials in the lab report, only revealing second- or third-line options if resistance to earlier choices is detected.
 Figure 1: Full AST report (left) vs Cascade report (right) - cascade reporting shows only first-line antimicrobials
Figure 1: Full AST report (left) vs Cascade report (right) - cascade reporting shows only first-line antimicrobials
While most veterinarians reported a preference for full AST data (59% vs 28% for full vs cascade), the results told a different story. When presented with cascade-style reports, veterinarians demonstrated a 26% increase in guideline-aligned decision-making compared to colleagues with complete AST data.
These findings align with evidence from human medicine, where cascade reporting has been shown to reduce the use of secondary or tertiary antimicrobials without compromising patient outcomes. Despite its success in human healthcare, cascade reporting remains underutilized and largely untested in veterinary medicine—at least until now.
Are We as AST-Savvy as We Think?
The study invites us to take a hard look in the mirror. While 72% of veterinarians reported feeling knowledgeable about interpreting AST reports, significant gaps in their understanding of AST were revealed:
- Many respondents incorrectly believed that each laboratory sets its own breakpoints
- Over half assumed that antimicrobials with the lowest minimum inhibitory concentration are always the best choice for systemic use
- Some veterinarians appeared to misunderstand key abbreviations—such as "IR" (intrinsic resistance)—and, as a result, requested susceptibility testing for antimicrobials to which the pathogen is intrinsically resistant
Even more telling, 68% of respondents reported using AST to directly select topical antimicrobials in otitis externa, suggesting a lack of awareness that AST is primarily designed for systemic antimicrobial therapy. As our practice shows, AST (together with culture, that is, pathogen identification) is used more as informative guidance in topical treatment rather than definitive instructions.
Encouragingly, 77% of participants acknowledged the need for further training, especially in interpreting AST data and selecting appropriate antimicrobials.
Validating What We Already Knew About AST in Practice
Some of the study's results confirmed what many of us have long suspected and experienced firsthand:
-
Interpretive comments matter: Over 80% of veterinarians reported that interpretive comments, antimicrobial and dosing recommendations, significantly improved the usefulness of AST reports.
-
Complex cases need specialist input: In more complex cases involving Pseudomonas aeruginosa, more than 50% of respondents indicated that they would consult a specialist, reflecting a common need for additional support when first-line options are limited or unclear.
-
Cost remains a barrier: Many veterinarians still don't submit AST samples regularly; in fact, 63% reported doing so less than once per week. The top-cited barrier? AST costs. This echoes what we see in the field: while stewardship is a shared goal, financial constraints remain significant hurdles to consistently implementing best practices. For a broader look at when testing adds value, see our guide on veterinary antibiogram testing and practical advice for culture and sensitivity testing in dogs.
Where Do We Go from Here?
This study echoes what we have long seen in the clinic: improving adherence to guidelines on antimicrobial use isn't just about access to big amounts of data—it's about how that data is delivered and understood. As veterinarians and veterinary microbiologic experts, it's time to rethink not just what we report but how.
Cascade AST reporting with explicit, interpretive comments on antimicrobial and dosing recommendations shall lead clinicians towards better, evidence-based clinical decisions.
How VetBac Helps
At VetBac, we understand these challenges firsthand. Our overnight antibiogram testing service provides:
 The VetBac solution: fast antibiogram testing with expert support
The VetBac solution: fast antibiogram testing with expert support
- Clear, actionable reports with interpretive guidance
- Cascade-style reporting that prioritizes first-line antimicrobials
- Expert support for complex cases via WhatsApp, email, or phone
- Affordable pricing to remove cost barriers to good stewardship
- Next-day results — learn more about how long culture and sensitivity testing takes
What's your experience with AST reporting in practice? Does your lab provide you with cascade reports? Contact us to discuss how we can help improve your antimicrobial stewardship.
Source: Rethinking AST Reporting in Veterinary Practice by Blaž Cugmas, PhD (LinkedIn, April 2025)
Reference: Diaz-Campos et al., JAVMA, DOI: 10.2460/javma.25.01.0045
Explore More Veterinary Insights
Ready to improve your antibiogram testing?
Get overnight results with clear, actionable reports.
Book a demo